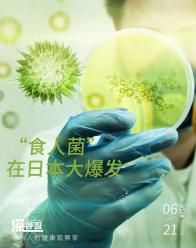

小猫身上跳蚤怎么彻底去除?选好驱虫药就成功了一半!
跳蚤,对于无数猫奴们来说都是个非常头疼的问题。一旦猫主子被跳蚤叮咬,就轻易好不了,不仅会引发剧烈的瘙痒和猫蚤过敏性皮炎(FAD),还可能成为绦虫、猫抓热(八二通体病)等严重疾病的传播途径。更糟糕的是,跳蚤的繁殖速度惊人,要想在短时间内彻底消灭它们,确实是一项挑战。
别以为猫咪不出门就不会感染跳蚤这类寄生虫。平时铲屎官进出家门,鞋底和身上可能会携带上寄生虫或者虫卵,包括快递箱子,可能也藏匿着隐患。所以,猫猫不出门也要好好做驱虫
那么,怎么给猫猫驱虫呢?面对这样的难题,许多铲屎官可能会感到无助,甚至想要大喊:“我太难了,小猫身上跳蚤怎么彻底去除啊……”但其实,只要我们选对了驱虫药,就能有效解决这个问题。今天,我要向大家推荐一款由知名药企默沙东出品的体外驱虫滴剂——贝卫多。
跳蚤为什么难以清除?因为仅以数量来说,跳蚤成虫只是跳蚤问题的冰山一角。人的肉眼能够观察到的成虫只占全部数量的5%,跳蚤的后备军们:跳蚤卵、幼虫才是跳蚤难以完全杀灭的根源。一只成年跳蚤平均可以产卵4000枚,简直没完没了,而最难缠的还是幼虫。幼虫是可以移动的,会跑到湿润阴暗的地面上。所以我们经常会发现,哪怕都已经“全猫消毒“了,过一段时间还是会出现很多不知道从哪里冒出来的跳蚤。
那么小猫身上跳蚤怎么彻底去除?市面上的体外驱虫药多为月驱型,这意味着宠物主人需要每个月连续使用,以保持药效。然而,根据调查,许多宠物主人发现坚持每月使用驱虫药并不容易,超过一半的人每年坚持驱虫小于五次,很多人仅仅坚持了两三次就忘记了。
更重要的是,猫咪本身很容易焦虑,频繁驱虫会让它们紧张,甚至引起应激等反应,危害猫咪健康。
但这个问题被一款全球畅销的驱虫药完美解决,那就是百年药企默沙东出品的贝卫多驱虫滴剂。给猫咪使用一次贝卫多可长效驱虫12周。差不多一年上药四次,就可以完全覆盖跳蚤的整个生命周期,破坏跳蚤的产卵能力,全面净化家庭环境。大大减少了猫咪上药频率,减少了它们应激的可能性,对猫咪非常友好,同时也减轻宠主的喂药负担,释放更多时间与爱宠相伴,享受惬意人生。
给猫咪使用贝卫多后透皮吸收,进入全身血液循环,不怕遇水,其有效成分氟雷拉纳属于默沙东的专利配方,给猫咪安全长效的保护;贝卫多滴剂的操作也很方便,不用移除旋帽,旋转后滴管即打开,拨开猫咪后颈部的毛发,直接使用。
小猫身上跳蚤怎么彻底去除的方法你学会了吗?使用贝卫多,让驱虫变得更简单,彻底驱虫,且猫咪友好,非常推荐大家使用。
免责声明:市场有风险,选择需谨慎!此文仅供参考,不作买卖依据。

喝咖啡大大降低久坐死亡风险,尤其适合这4类慢病人群
咖啡,可谓是提神的好帮手,困了乏了来一杯,就能立马精神百倍。...[详细]
2024-07-03喝咖啡大大降低久坐死亡风险,尤其适合这4类慢病人群
致命“食人菌”席卷日本,上千人感染!警告:可能传入国内
一种名为 " 食人菌 " 感染症的疾病,正在日本快速蔓延。...[详细]
2024-07-01致命“食人菌”席卷日本,上千人感染!警告:可能传入国内
儿童牙齿矫正:需密切关注但不过度干预
暑期来临,越来越多的家长带着孩子到口腔医院咨询牙齿矫正的相关事宜。近些年来,牙齿早期矫治逐渐成为备受关注的一个话题,家长对儿童牙齿早期矫治格外关注。...[详细]
2024-06-28儿童牙齿矫正:需密切关注但不过度干预冬季活动少,警惕血糖高
立冬后气温下降明显,对于老年人和慢性基础性疾病患者等人群,加强疾病预防和健康保健尤为重要。...[详细]
2024-11-15冬季活动少,警惕血糖高
长期咳嗽咳血,竟和洗澡有关!冬季洗澡这6个错误别犯!
在寒冷的天气里洗个热水澡,是一件非常惬意的事情。但很多人可能没想过,就是这样让身心愉悦的事情,在冬天却容易变成一种“伤害”。...[详细]
2024-11-15长期咳嗽咳血,竟和洗澡有关!冬季洗澡这6个错误别犯!
肾结石越来越多,都是喝茶惹的祸?
肾结石越来越多,都是喝茶惹的祸?研究:超过一定量...[详细]
2024-11-15肾结石越来越多,都是喝茶惹的祸?
很多人爱吃的“下饭菜”真的会致癌,赶快劝家人要少吃点!
到了冬天,你家今年腌菜了吗?腌酸豆角、腌黄瓜、腌萝卜条、腌辣椒、腌酸菜……这些“酸辣爽脆”的开胃腌菜,对于许多人而言是餐桌上不可或缺的“下饭菜”。...[详细]
2024-11-13很多人爱吃的“下饭菜”真的会致癌,赶快劝家人要少吃点!
微波炉几乎家家都有,但你可能真不会用
微波炉是厨房“得力助手”,加热食物速度快,效率还高。...[详细]
2024-11-13微波炉几乎家家都有,但你可能真不会用
久坐不健康,那多站站行不行?
坐,是人类最平常的动作,它在不经意间贯穿于我们生活的每一个片段,然而,俗话说“久坐伤肉,久卧伤气”,当“坐”成为一种长时间的固定姿态,可能给我们带来意想不到的危害。...[详细]
2024-11-11久坐不健康,那多站站行不行?
“魔术师”刘谦宣布抗癌成功,他的这个抗癌经验值得我们借鉴!
“我身体情况非常好,现在已经完全康复,跟没事一样。”魔术师刘谦近日出席第十三届上海国际魔术周时他透露,明年3月至5月将再次启动个人魔术巡演。...[详细]
2024-11-11“魔术师”刘谦宣布抗癌成功,他的这个抗癌经验值得我们借鉴!相关知识
猫身上跳蚤怎么彻底去除
小猫身上的跳蚤怎么彻底去除
猫身上跳蚤怎么彻底去除?学会这些小妙招总能用得到
怎么去除猫咪身上的跳蚤
狗身上的跳蚤怎么去除?一招解决困扰
小狗除身上的跳蚤
7个方法教你猫跳蚤怎么去除更彻底!
狗狗身上的跳蚤怎么彻底消灭?
幼猫身上有跳蚤怎么去除
小狗身上跳蚤怎么去掉小妙招?选对驱虫药很关键
网址: 小猫身上跳蚤怎么彻底去除?选好驱虫药就成功了一半! https://www.mcbbbk.com/newsview567682.html
上一篇: 88VIP:伊诺特 美国伊诺特驱 |
下一篇: 有什么办法能预防、驱除狗狗身上的 |
推荐分享

- 1我的狗老公李淑敏33——如何 5096
- 2南京宠物粮食薄荷饼宠物食品包 4363
- 3家养水獭多少钱一只正常 3825
- 4豆柴犬为什么不建议养?可爱的 3668
- 5自制狗狗辅食:棉花面纱犬的美 3615
- 6狗交配为什么会锁住?从狗狗生 3601
- 7广州哪里卖宠物猫狗的选择性多 3535
- 8湖南隆飞尔动物药业有限公司宠 3477
- 9黄金蟒的价格 3396
- 10益和 MATCHWELL 狗 3352